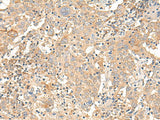
CORO2A Polyclonal Antibody Reactivity Human

CORO2A Polyclonal Antibody Reactivity Human
SKU: E-AB-52651-200
CORO2A Polyclonal Antibody Reactivity Human
| SKU # | E-AB-52651 |
| Reactivity | Human |
| Host | Rabbit |
| Applications | IHC |
Product Details
| Isotype | IgG |
| Host | Rabbit |
| Reactivity | Human |
| Applications | IHC |
| Clonality | Polyclonal |
| Immunogen | Fusion protein of human CORO2A |
| Abbre | CORO2A |
| Synonyms | CLIPINB, COR2A, CORO 2A, CORO2A, Coronin 2A, Coronin actin binding protein 2A, Coronin like protein B, Coronin-2A, DKFZp686G19226, IR10, OTTHUMP00000021767, OTTHUMP00000021768, WD protein IR10, WD repeat containing protein 2, WD repeat protein 2, WD repeat-containing pr |
| Swissprot | |
| Concentration | 0.54 mg/mL |
| Buffer | Phosphate buffered solution, pH 7.4, containing 0.05% stabilizer and 50% glycerol. |
| Purification Method | Antigen affinity purification |
| Research Areas | Epigenetics and Nuclear Signaling, Signal transduction |
| Conjugation | Unconjugated |
| Storage | Store at -20°C Valid for 12 months. Avoid freeze / thaw cycles. |
| Shipping | The product is shipped with ice pack, upon receipt, store it immediately at the temperature recommended. |
Related Reagents
| Applications | Recommended Dilution |
| IHC | 1:30-1:150 |
Background
This gene encodes a member of the WD repeat protein family. WD repeats are minimally conserved regions of approximately 40 amino acids typically bracketed by gly-his and trp-asp (GH-WD), which may facilitate formation of heterotrimeric or multiprotein complexes. Members of this family are involved in a variety of cellular processes, including cell cycle progression, signal transduction, apoptosis, and gene regulation. This protein contains 5 WD repeats, and has a structural similarity with actin-binding proteins: the D. discoideum coronin and the human p57 protein, suggesting that this protein may also be an actin-binding protein that regulates cell motility. Alternative splicing of this gene generates 2 transcript variants.